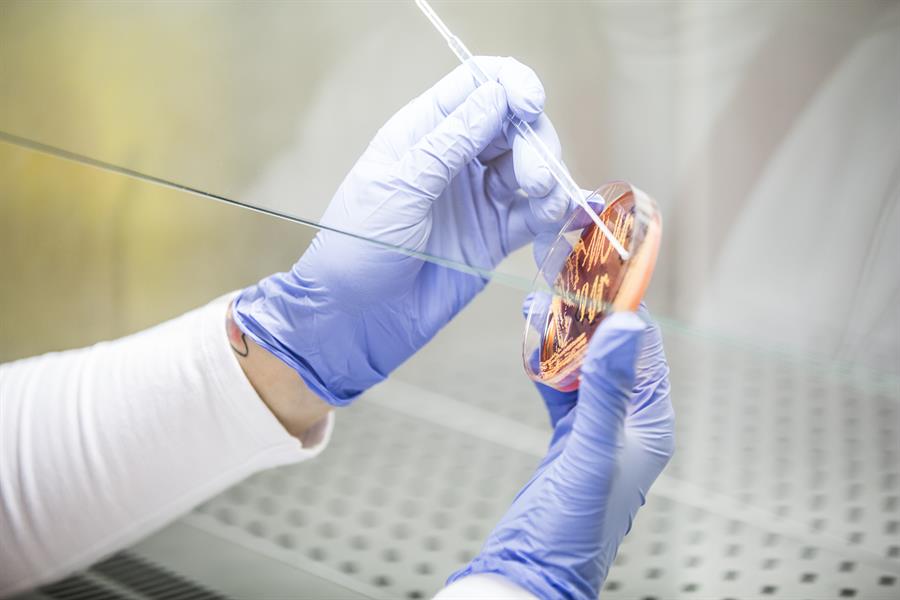
Laboratorio Analisi

L'anticorpo anticolesterolo che promette di più
La conferma da studi internazionali guidati da Centro Cardiologico Monzino e Università degli Studi di Milano
La proteina PCSK9 da qualche tempo sta entusiasmando gli scienziati. Pochi anni fa la scoperta del suo ruolo chiave nell’ipercolesterolemia, oggi le evidenze della sua azione cruciale anche nell’attivazione e nell’aggregazione delle piastrine, all’origine dei processi trombotici che scatenano infarti e ictus, e persino nella calcificazione della valvola aortica. Le prime conferme arrivano da due studi internazionali guidati dal Centro Cardiologico Monzino e dall’Università degli Studi di Milano, pubblicati su JACC (Journal of the American College of Cardiology) e condotti da Marina Camera, responsabile dell’ Unità di ricerca di Biologia cellulare e molecolare cardiovascolare presso il Cardiologico Monzino e professoressa di farmacologia presso l’Università degli Studi di Milano, e da Paolo Poggio, alla guida dell’ Unità per lo studio delle patologie aortiche, valvolari e coronariche dell’IRCCS milanese.
L’anticorpo anti-colesterolo che promette di più
Con gli inibitori di PCSK9, anticorpi monoclonali in grado di disattivare questa proteina, è stato possibile contrastare con successo l’ipercolesterolemia, fino a raggiungere una riduzione del colesterolo LDL del 60-70%, in particolare nelle forme più severe e resistenti al trattamento con i farmaci tradizionalmente in uso e nei pazienti trattati si è ottenuta una riduzione del rischio del 15% di eventi come infarto e ictus. D’altra parte è stato riscontrato che i soggetti che geneticamente hanno livelli ridotti di PCSK9 sono protetti dall'incidenza di eventi cardiovascolari. «Questi dati - sottolinea la professoressa Marina Camera (nella foto) - ci hanno spinto a ipotizzare che i benefici in termini di eventi cardiovascolari prevenuti bloccando PCSK9 potessero dipendere non soltanto dalla riduzione di colesterolo ottenuta. Abbiamo pensato che potesse esserci di più, che l’azione di questa proteina potesse estendersi oltre il metabolismo dei lipidi, e così abbiamo iniziato a cercare».
La proteina PCSK9 interviene anche nello sviluppo di infarto e ictus
Si era già osservato, del resto, che un elevato livello di PCSK9 nel sangue fosse un predittore di eventi cardiovascolari nei pazienti con malattia coronarica e con fibrillazione atriale. E uno studio genomico aveva rilevato una correlazione tra alti livelli di PCSK9 e la presenza di stenosi calcifica della valvola aortica. «Abbiamo così avviato nei nostri laboratori studi in vitro ed ex vivo con esiti sorprendenti», dichiara la professoressa Camera. «È emerso infatti che PCSK9 ha un ruolo cruciale nell’attivazione delle piastrine umane, nella loro capacità di aggregarsi formando i trombi che, a loro volta, provocano infarti e ictus» - spiega la professoressa. «Questo potrebbe essere pertanto uno dei meccanismi responsabili della maggior incidenza di eventi cardiovascolari riscontrati nei pazienti affetti da patologia coronarica e fibrillazione atriale».
E ha un ruolo nella calcificazione della valvola aortica, patologia in crescita
C’è di più. «I nostri dati hanno evidenziato l’esistenza di un effetto diretto di PCSK9 sullo sviluppo e la progressione della stenosi calcifica della valvola aortica ed è un’osservazione che ci entusiasma profondamente incoraggiandoci a proseguire su questa linea di ricerca» - spiega Paolo Poggio (nella foto). «Ricordiamo che negli ultimi decenni tutti gli sforzi fatti per mettere a punto una terapia medica in grado di prevenire o fermare la progressione della malattia non hanno portato i risultati sperati. Per i malati di stenosi valvolare aortica attualmente le prospettive terapeutiche sono l’intervento chirurgico o percutaneo. Per questa ragione guardiamo con speranza alla prospettiva che l’inibizione di PCSK9 possa rappresentare una nuova possibilità terapeutica: significherebbe segnare una svolta nel trattamento di questa malattia degenerativa, piuttosto comune nella popolazione anziana. Nei paesi sviluppati la stima raggiunge il 7% negli over 65 ed è un numero in crescita considerando l’invecchiamento della popolazione».
I risultati ottenuti sono solo un punto di partenza. Dovremo infatti avviare nuovi studi clinici, e abbiamo la necessità e il desiderio di comprendere quali siano i meccanismi molecolari che stanno alla base dei fenomeni osservati. Per il momento ciò che ci sembra davvero evidente è che questa proteina gioca un ruolo nella nostra salute cardiovascolare che si estende ben oltre il controllo del colesterolo agendo su molteplici fronti, e apre davanti a noi scenari di prevenzione e cura davvero promettenti.